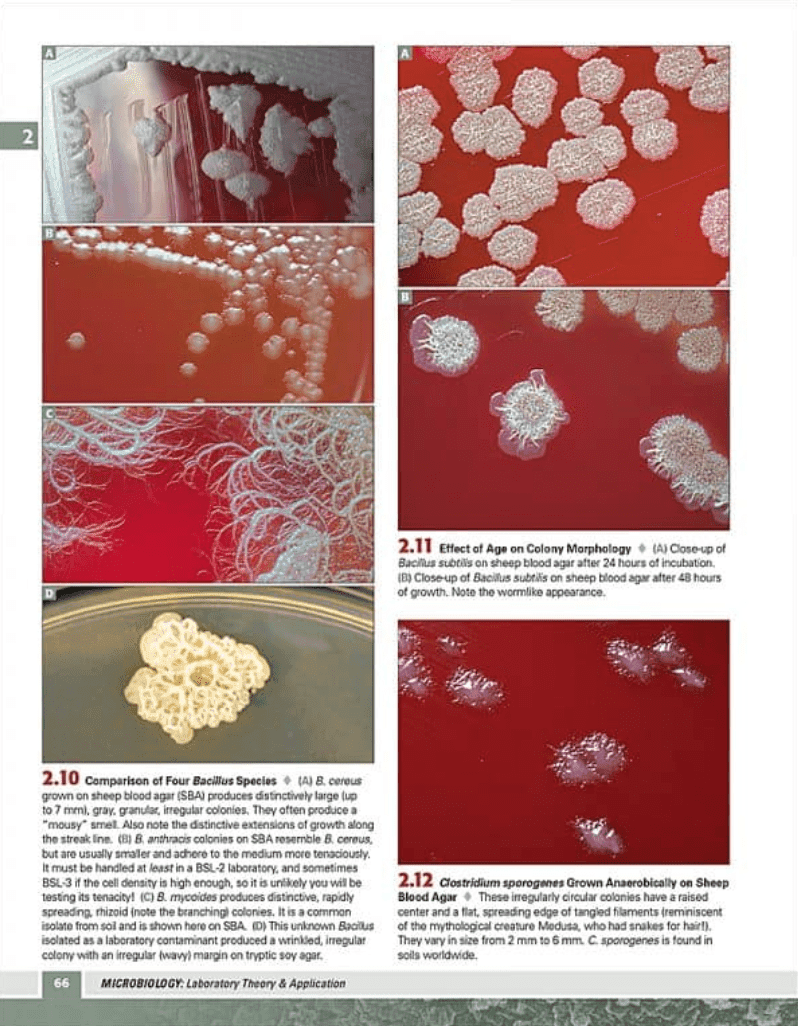

Microbiology: Laboratory Theory & Application, 4e
Michael J. Leboffe, Burton E. Pierce
Beautiful full-color photography, effective illustrations, carefully written exercises, and a reasonable price combine to make Microbiology: Laboratory Theory & Application the best-selling microbiology lab manual series on the market. The Theory and Application sections provide students with the general principles and everyday purpose of the labs, empowering them to make connections between course concepts and the real world. This edition satisfies the content needs of courses populated by majors or in non-majors courses where they need an increased coverage of applied microbiology.

Top Hat Interactive eText
requires a join code from instructor
$83.00USD
all prices represent net price, not including 3rd party markups
ISBN: 9781617312502
does not require a join code
$106.00USD
all prices represent net price, not including 3rd party markups

Table of Contents for Microbiology: Laboratory Theory & Application, 4e
- MLTA Preliminaries
- MLTA Introduction
- Exercise 1-1: A Comparison of Hand-Cleansing Agents
- Exercise 1-2: Nutrient Broth and Nutrient Agar Preparation
- Exercise 1-3: Common Aseptic Transfers and Inoculation Methods
- Exercise 1-4: Streak Plate Methods of Isolation
- Exercise 1-5: Spread Plate Method of Isolation
- Exercise 2-1: Ubiquity of Microorganisms
- Exercise 2-2: Colony Morphology
- Exercise 2-3: Growth Patterns on Slants
- Exercise 2-4: Growth Patterns in Broth
- Exercise 2-5: Evaluation of Media
- Exercise 2-6: Agar Deep Stabs
- Exercise 2-7: Fluid Thioglycollate Broth
Key features
- High-quality, full-color photographs, micrographs, and illustrations ensure that students have color-accurate visual representations of what they will see in the lab
- 119 exercises covering a full selection of clinical and applied microbiology topics
- Theory and Application provide students with the general principles and everyday purpose of the labs
- In This Exercise clearly explains what students can expect as they work through the lab procedures